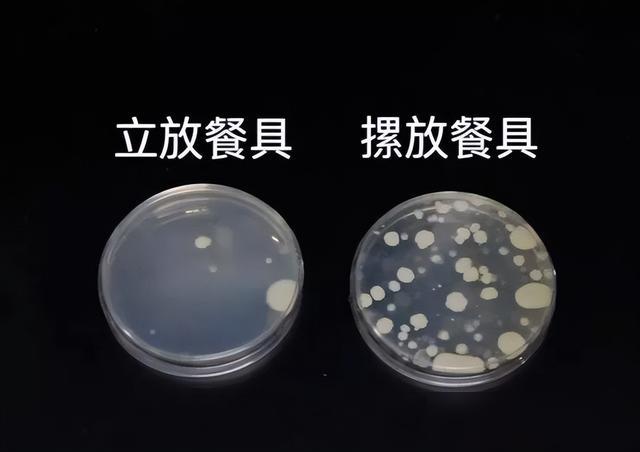

真的吓一跳!最近刷到好多人说,洗碗时用脏抹布、泡碗半天、用劣质洗洁精、碗摞碗这些习惯,其实全是细菌“窝点”! 可不能再不当回事了!洗碗是跟家人入口的东西打交道,错一步就是把细菌往肚子里送,对家人健康太不负责! 咱们天天变着花样给家人做饭,不就是图个干净安心吗?洗碗这收尾活要是糊弄,前面的用心全白费! 咱们中国人最讲“民以食为天”,食的安全从洗碗开始!你家有没有这些坏习惯?快提醒家人改,一起把细菌挡在碗外面!







真的吓一跳!最近刷到好多人说,洗碗时用脏抹布、泡碗半天、用劣质洗洁精、碗摞碗这些习惯,其实全是细菌“窝点”! 可不能再不当回事了!洗碗是跟家人入口的东西打交道,错一步就是把细菌往肚子里送,对家人健康太不负责! 咱们天天变着花样给家人做饭,不就是图个干净安心吗?洗碗这收尾活要是糊弄,前面的用心全白费! 咱们中国人最讲“民以食为天”,食的安全从洗碗开始!你家有没有这些坏习惯?快提醒家人改,一起把细菌挡在碗外面!

作者最新文章
热门分类
社会TOP
社会最新文章